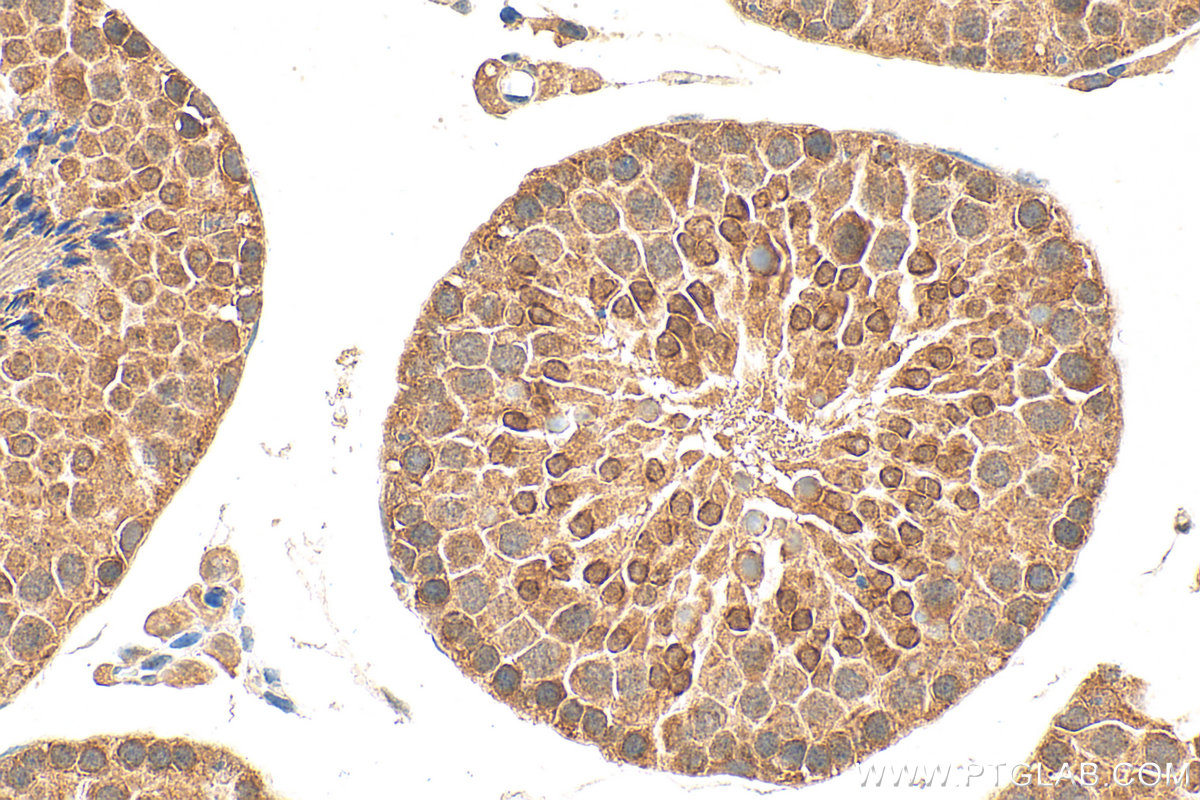
Immunohistochemical analysis of paraffin-embedded mouse testis tissue slide using 17810-1-AP (RNF4 antibody) at dilution of 1:2000 (under 40x lens). Heat mediated antigen retrieval with Tris-EDTA buffer (pH 9.0). IHC staining of mouse testis using 17810-1-AP

验证数据展示
经过测试的应用
| Positive WB detected in | PC-3 cells, HepG2 cells |
| Positive IP detected in | PC-3 cells |
| Positive IHC detected in | mouse testis tissue Note: suggested antigen retrieval with TE buffer pH 9.0; (*) Alternatively, antigen retrieval may be performed with citrate buffer pH 6.0 |
推荐稀释比
| 应用 | 推荐稀释比 |
|---|---|
| Western Blot (WB) | WB : 1:500-1:1000 |
| Immunoprecipitation (IP) | IP : 0.5-4.0 ug for 1.0-3.0 mg of total protein lysate |
| Immunohistochemistry (IHC) | IHC : 1:1000-1:4000 |
| It is recommended that this reagent should be titrated in each testing system to obtain optimal results. | |
| Sample-dependent, Check data in validation data gallery. | |
发表文章中的应用
| KD/KO | See 5 publications below |
| WB | See 10 publications below |
| CoIP | See 1 publications below |
产品信息
17810-1-AP targets RNF4 in WB, IHC, IP, CoIP, ELISA applications and shows reactivity with human, mouse, rat samples.
| 经测试应用 | WB, IHC, IP, ELISA Application Description |
| 文献引用应用 | WB, CoIP |
| 经测试反应性 | human, mouse, rat |
| 文献引用反应性 | human, mouse |
| 免疫原 |
CatNo: Ag12115 Product name: Recombinant human RNF4 protein Source: e coli.-derived, PGEX-4T Tag: GST Domain: 1-190 aa of BC031935 Sequence: MSTRKRRGGAINSRQAQKRTREATSTPEISLEAEPIELVETAGDEIVDLTCESLEPVVVDLTHNDSVVIVDERRRPRRNARRLPQDHADSCVVSSDDEELSRDRDVYVTTHTPRNARDEGATGLRPSGTVSCPICMDGYSEIVQNGRLIVSTECGHVFCSQCLRDSLKNANTCPTCRKKINHKRYHPIYI 种属同源性预测 |
| 宿主/亚型 | Rabbit / IgG |
| 抗体类别 | Polyclonal |
| 产品类型 | Antibody |
| 全称 | ring finger protein 4 |
| 别名 | E3 ubiquitin ligase RNF4, E3 ubiquitin-protein ligase RNF4, EC:2.3.2.27, Protein SNURF, RES4 26 |
| 计算分子量 | 190 aa, 21 kDa |
| 观测分子量 | 30 kDa |
| GenBank蛋白编号 | BC031935 |
| 基因名称 | RNF4 |
| Gene ID (NCBI) | 6047 |
| RRID | AB_2878443 |
| 偶联类型 | Unconjugated |
| 形式 | Liquid |
| 纯化方式 | Antigen affinity purification |
| UNIPROT ID | P78317 |
| 储存缓冲液 | PBS with 0.02% sodium azide and 50% glycerol, pH 7.3. |
| 储存条件 | Store at -20°C. Stable for one year after shipment. Aliquoting is unnecessary for -20oC storage. |
背景介绍
RNF4 is a E3 ubiquitin-protein ligase that binds polysumoylated chains covalently attached to proteins and mediates 'Lys-6'-, 'Lys-11'-, 'Lys-48'- and 'Lys-63'-linked polyubiquitination of those substrates and their subsequent targeting to the proteasome for degradation. It regulates the degradation of several proteins including PML and PEA3[PMID:18408734]. It also participates in chromosome alignment and spindle assembly, and regulates the kinetochore CENPH-CENPI-CENPK complex by targeting polysumoylated CENPI to proteasomal degradation. In addition, RNF4 can regulates the cellular responses to hypoxia and heat shock through degradation of respectively EPAS1 and PARP1 [PMID:20026589]. Alternatively, it may also bind DNA/nucleosomes and have a more direct role in the regulation of transcription for instance enhancing basal transcription and steroid receptor-mediated transcriptional activation [PMID:11319220]. RNF4 exist as two isoforms. Isoform one is a 30 kDa protein and isoform two is a about 15 kDa protein. RNF4 binds polysumoylated chains and the molecular weight of RNF4 migrate in the experiment to 35 kDa, 47 kDa, 69 kDa as ubiquitinated protein.
实验方案
| Product Specific Protocols | |
|---|---|
| IHC protocol for RNF4 antibody 17810-1-AP | Download protocol |
| IP protocol for RNF4 antibody 17810-1-AP | Download protocol |
| WB protocol for RNF4 antibody 17810-1-AP | Download protocol |
| Standard Protocols | |
|---|---|
| Click here to view our Standard Protocols |
发表文章
| Species | Application | Title |
|---|---|---|
Cell TEX264 drives selective autophagy of DNA lesions to promote DNA repair and cell survival | ||
Adv Sci (Weinh) Meisoindigo Acts as a Molecular Glue to Target PKMYT1 for Degradation in Chronic Myeloid Leukemia Therapy | ||
Nat Commun Crosstalk between SUMOylation and ubiquitylation controls DNA end resection by maintaining MRE11 homeostasis on chromatin | ||
Int J Mol Sci The E3 Ubiquitin-Protein Ligase RNF4 Promotes TNF-α-Induced Cell Death Triggered by RIPK1. | ||
ACS Chem Biol Covalent Ligand Screening Uncovers a RNF4 E3 Ligase Recruiter for Targeted Protein Degradation Applications. | ||
J Biol Chem Analysis of a degron-containing reporter protein GFP-CL1 reveals a role for SUMO1 in cytosolic protein quality control
|